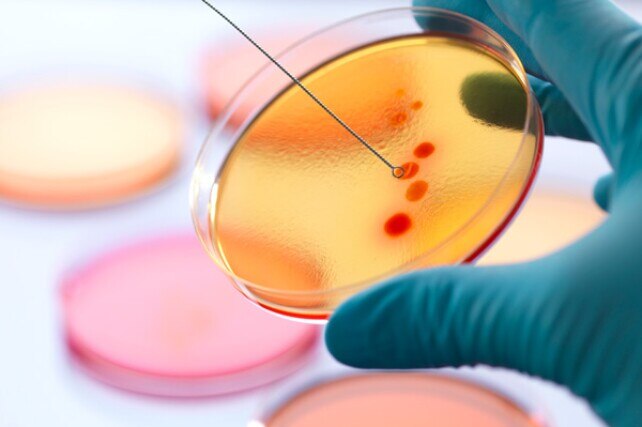
scientist collecting a sample from a petri dish

Gezondheid & Levenswetenschappen
Advancing Health Technology Agendas
Schone, gezonde gegevens voor innovatie, inzicht en betere zorg
Levert u zorg, of ontwikkelt u software? Ben je een data wetenschapper, of een lab wetenschapper? Besteed je je tijd aan het uitvinden van medische technologie, of het testen van het volgende vaccin? Optimaliseert u het betalingsbeleid voor een commerciële betaler, of beheert u het gezondheidsbeleid voor een van 's werelds grootste steden?
Wat uw rol of doel ook is, als u afhankelijk bent van gezondheidsinformatie kunt u vertrouwen op InterSystems.
Wat uw rol of doel ook is, als u afhankelijk bent van gezondheidsinformatie kunt u vertrouwen op InterSystems.

Gedreven door gegevens
Van het registreren van de APGAR-score binnen enkele ogenblikken na de geboorte tot de in-silica-zoektocht naar het volgende baanbrekende geneesmiddel: de gezondheidszorg en de biowetenschappen zijn afhankelijk van gegevens.
Gegevens om ziekten te diagnosticeren, de zorg te beheren, ziekenhuizen te runnen, bevoorradingsketens aan te drijven en betalingen te verantwoorden. Gegevens om onderzoek en ontdekkingen te voeden, de doeltreffendheid te meten en het gezondheidsbeleid te onderbouwen. Data to advance insight.
Net zoals de vooruitgang op het gebied van volksgezondheid in de 19e eeuw grotendeels te danken was aan investeringen in overvloedig, schoon water, zal de vooruitgang op het gebied van digitale gezondheid in de 21e eeuw te danken zijn aan overvloedige, schone, gezonde gegevens. Geen enkel bedrijf kent gezondheidsgegevens zoals InterSystems.
Net zoals de vooruitgang op het gebied van volksgezondheid in de 19e eeuw grotendeels te danken was aan investeringen in overvloedig, schoon water, zal de vooruitgang op het gebied van digitale gezondheid in de 21e eeuw te danken zijn aan overvloedige, schone, gezonde gegevens. Geen enkel bedrijf kent gezondheidsgegevens zoals InterSystems.
Geen enkel bedrijf kent gezondheidsgegevens zoals InterSystems.
De cijfers liegen niet.
1 Miljard+
Wereldwijd worden meer dan 1 miljard gezondheidsdossiers beheerd met technologie van InterSystems.
2 van 3
Grote EHR-producten die Gartner "Global Solutions" noemt, draaien op technologie van InterSysems.
Alle 20
Instellingen in de U.S. News & World Report 2020 Honor Roll of Best Hospitals gebruiken producten van InterSystems

Producten
Aangedreven door interoperabiliteit
Gezonde gegevens zijn nutteloos als ze niet vrij kunnen stromen binnen organisaties, tussen gemeenschappen, tussen informatiesystemen, van apparaten naar apps, en van zorgverleners naar innovatoren.
Interoperabiliteitsnormen zoals FHIR maken de vrije stroom van gegevens mogelijk door ervoor te zorgen dat zij van begin tot eind door systemen en mensen op dezelfde manier worden begrepen. Daarom investeert InterSystems in interoperabiliteit, en doet dat al tientallen jaren. Daarom bouwen we FHIR vanaf het begin in onze hele technologiestapel in.

Inzicht op schaal
InterSystems technologie en oplossingen zorgen voor intelligente klinische workflows en real-time beslissingsondersteuning overal waar zorgbeslissingen worden genomen.
Zij leveren de analytische gegevens om een organisatie - of de gezondheid van een populatie - te beheren. Ze zijn gebouwd om de grootste datameren te ontginnen door middel van machine learning en discovery. En ze leveren de mogelijkheden die u nodig hebt om uw eigen
smart health data fabric samen te stellen.
Wij zijn verbonden met en geïntegreerd in bijna 200 verschillende gezondheidsinformatiesystemen, waaronder die van Epic, Cerner en Allscripts.
InterSystems Gezondheidszorg Technologie Oplossingen
InterSystems HL7® FHIR® -gebaseerde technologie en oplossingen dragen bij aan het succes van de volgende groepen mensen.
Aanbieders
Gebruik gezonde gegevens voor analyses en collaboratieve zorg
Betalers
Samenwerking tussen betalers en leveranciers, naleving van de regelgeving en de verschuiving naar op waarde gebaseerde zorg
14 jun 2022
Regering
Ondersteuning van de gezondheidszorg in de publieke sector met EHR- en interoperabiliteitsoplossingen
MedTech Vernieuwers
Versnelde ontwikkeling van oplossingen voor digitale gezondheid
Software Ontwikkelaars
Creëer digitale gezondheidsoplossingen met een innovatief ontwikkelplatform
Biowetenschappelijke bedrijven
Toegang tot realtime, real-world gegevens om uw innovatie te versnellen
Klinische laboratoria
Bouw uw eigen next-gen lab oplossing of maak gebruik van TrakCare Lab Enterprise
Betere beslissingen voor de zorg. Betere inzichten voor het management. Betere gegevens voor analyse en AI.
Of u nu op zoek bent naar een kant-en-klare softwareoplossing om de zorg te beheren of een zorgspecifiek dataplatform om oplossingen te ontwikkelen, InterSystems kan u helpen.
InterSystems IRIS for Health-platform voor gegevensbeheer
InterSystems IRIS for Health™ is 's werelds eerste en enige dataplatform dat specifiek is ontworpen om waarde te halen uit gegevens voor de gezondheidszorg. Het stelt u in staat om snel de volgende baanbrekende toepassingen in de gezondheidszorg te creëren en te schalen.
Meer over InterSystems IRIS for Health
Meer over InterSystems IRIS for Health
InterSystems HealthShare interoperabiliteitsplatform
InterSystems HealthShare verbindt leveranciers, patiënten en betalers via een uniform zorgdossier en analyses die het zorgcontinuüm overspannen.
Meer over InterSystems HealthShare
Meer over InterSystems HealthShare
InterSystems TrakCare® wereldwijd gezondheidsinformatiesysteem
InterSystems TrakCare verenigd zorginformatiesysteem is voor organisaties die een verschil willen maken in de zorg door het transformeren van zorgverlening en de ervaring van de patiënt. Het is voor organisaties die serieus werk willen maken van digitale transformatie.
Meer over InterSystems TrakCare
Meer over InterSystems TrakCare
InterSystems TrakCare Lab Enterprise wereldwijd laboratoriuminformatiesysteem
InterSystems TrakCare® Lab Enterprise maakt van uw laboratorium een informatiegestuurd, verbonden bedrijf. Het omvat wereldwijde best practices, het resultaat van InterSystems' succesvolle implementaties van laboratoriumsoftware in meer dan 400 laboratoria in 25 landen.
InterSystems HealthShare Health Connect integratiemotor
InterSystems HealthShare Health Connect is een integratie-engine die transactieondersteuning voor grote volumes, procesbeheer en monitoring levert om bedrijfskritische toepassingen te ondersteunen.
Meer over InterSystems HealthShare Health Connect
Meer over InterSystems HealthShare Health Connect
InterSystems end-to-end analyseoplossing voor de gezondheidszorg
Wanneer je een wereldwijde gezondheidszorg van 8,45 biljoen dollar combineert met een gegevensgroei die 60% groter is dan in andere sectoren en een missie van leven of dood, dan is het resultaat een enorme behoefte aan analytics in de gezondheidszorg. InterSystems plaatst analyse in het middelpunt van alles wat we bouwen.
Meer over InterSystems Analytics-oplossing voor de gezondheidszorg
Meer over InterSystems Analytics-oplossing voor de gezondheidszorg